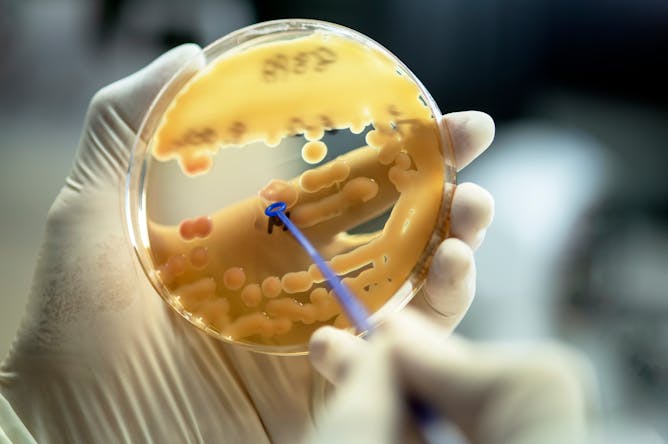

|
Since the beginning of February we’ve been introducing you to the various microbes that live inside your gut. We’ve discussed Roseburia intestinalis, the microbe that helps produce the energy our cells need to fight disease. And we've looked at Bifidobacterium breve, the species that’s key for newborns in building a healthy gut. But as we’ve also learned from bacteria such as Bilophila wadsworthia, not all of the microbes that call our gut home are always friendly.
This is the case with Klebsiella pneumoniae. This microbe is the most common cause of pneumonia in hospital patients and the second most frequent cause of urinary tract infections. If it gets into a wound it can also cause sepsis.Yet it isn’t only people who are sick or undergoing hospital treatment who have K pneumoniae living in their microbiome. There’s actually a chance that this bacterium is already lurking inside your gut.
An estimated 4% of the population has this bacterial strain living in their gut microbiome. But the reasons why some of us get sick from K pneumoniae, and for others it remains a harmless microbe, is something researchers are still trying to uncover — and many think the wider microbiome holds the answer.
Elsewhere, a recent case study has provided researchers with new insights into a rare condition that affects the way some perceives faces. Prosopometamorphopsia, a disorder suffered by Pablo Picasso and Francis Bacon, can make faces appear distorted — and at times even demonic. This latest study has allowed researchers for the first time to create visualisations of what the distortions look like to those who suffer with the condition.
Nato members are due to meet this Thursday, in what will be the 75th anniversary of the group. We hear why world leaders should be thinking about ways to Trump-proof their policies now – even though we don't yet know if Donald Trump will be re-elected.
|

|
Heather Kroeker
Commissioning Editor, Health
|
|
K pneumoniae is the most common cause of hospital-aquired pneumonia.
AnaLysiSStudiO/ Shutterstock
Frances Spragge, University of Oxford
Some strains of this opportunistic pathogen are also increasingly becoming resistant to the drugs designed to treat them.
|

A. Mello et al
Robin Kramer, University of Lincoln
A highly unusual new case is giving scientists insights about what causes illusions of facial distortion
|

Donald Trump has an uneasy relationship with Nato, and has said the US would rethink its relationship if he is re-elected.
Xinhua/Alamy Stock Photo
Michelle Bentley, Royal Holloway University of London
If the world sits on the sidelines for the next six months, it not only loses time and ground but puts Trump in a stronger position if he is elected.
|
Health
|
-
Dan Baumgardt, University of Bristol
Is brain transplant surgery the stuff of dark Hollywood fairytales or a feasible possibility?
-
Primrose Freestone, University of Leicester
If leftovers aren’t saved and reheated properly, it could put you at risk of food poisoning.
-
Julian Owen, Bangor University; Eloise Kirby, Bangor University
Despite the fact that there are similar injuries in men and women’s rugby, women should not be viewed merely as smaller versions of men.
|
|
Arts + Culture
|
-
Jessica Hughes, The Open University
The story of how a ‘new Pompeii’ was built is far less well known than that of the ancient city.
-
Adam Behr, Newcastle University
This Town echoes the ways in which music is forged by its social context, while shaping and defining the lives of the people who make it.
-
Beth Johnson, University of Leeds
The Disney series is a magical mega-mix of Sally Wainwright’s greatest hits.
|
|
Science + Technology
|
-
Dr Mohamed Shaheen, Loughborough University
We’ll need to learn the lessons from this disaster.
-
Marios Chryssanthopoulos, University of Surrey
The collapse of the Francis Scott Key bridge is already affecting global supply chains.
|
|
Environment
|
-
David Thomas, University of Oxford
Dunes can preserve a record of historic climate changes and shifting continents.
-
Tonya Lander, University of Oxford; Matthias Becher, University of Exeter
Check that something is blooming every week, March through October, to help bees.
|
|
World
|
-
Stefan Wolff, University of Birmingham
Russia has long harboured territorial ambitions in this former Soviet republic.
-
Jonathan Este, The Conversation
A selection of our coverage of the conflict from the past fortnight.
|
|
Business + Economy
|
-
Cristiana Bernardi, The Open University; John Dumay, Macquarie University; Stephanie Perkiss, University of Wollongong
The Chocolate Scorecard sets out the ethical credentials of ten of the biggest brands
|
|
Politics + Society
|
-
Paul O'Connor, University of Exeter
Skateparks show how the built environment can be transformed if communities, and the DIY cultures they give birth to, are allowed to flourish.
|
|
Education
|
-
Craig Smith, University of Salford
As the use of AI grows, so too will the advice clients seek on AI-related legal issues.
|
|
Podcasts
|
-
Mend Mariwany, The Conversation
Maxim Samson speaks to The Conversation Weekly podcast about the hidden lines that explain variations in everything from access to education to animal species
|
|
|
|
| |
|
|
8 March - 18 May 2024
•
Glasgow
|

|
29 March 2024
•
Winchester
|

|
8 April 2024
•
Manchester
|

|
11 April 2024
•
Portsmouth
|

|
|
|
|
| |
| |
| |
| |
| |
|
|